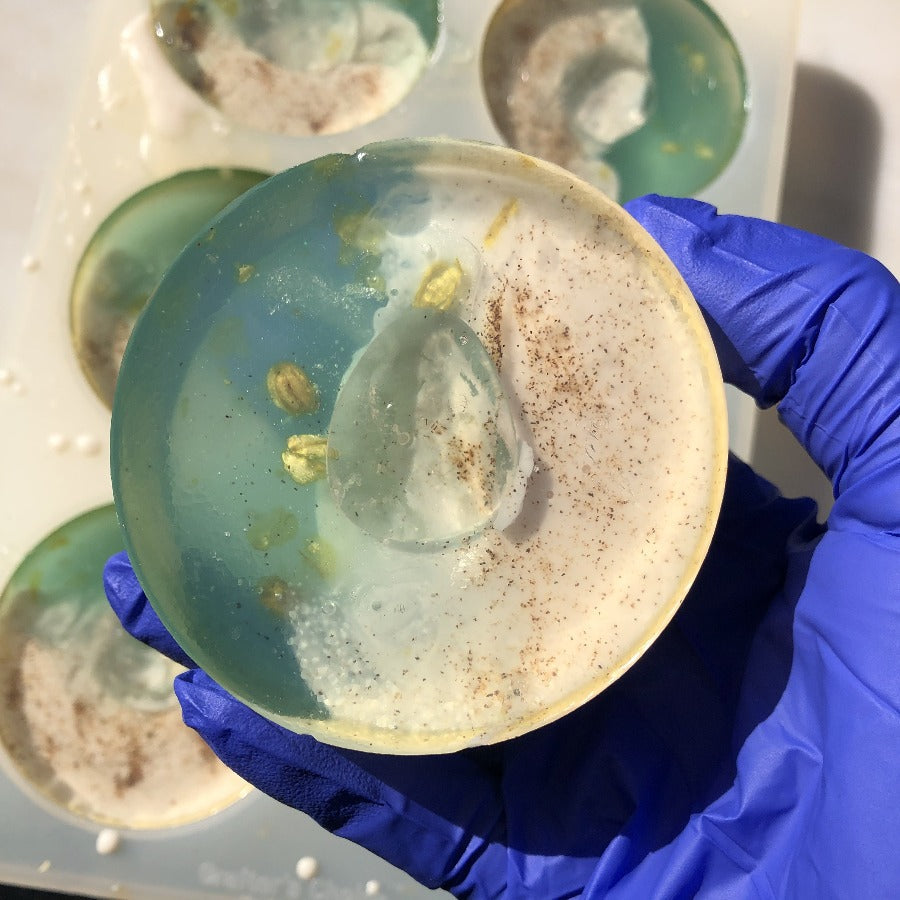
Beachy AF

Beachy AF
Beachy AF
This bar is inspired by white sands and clear blue waters. Have the beach in the palm of your hands along side clear quartz to amplify all your summer vibes and manifestations. Made with Shea Butter, Oatmeal and walnut shells for a little scrubby action just like the beach. Scented in Abalone and Sea. It's almost like your there, just close your eyes :)
Clear Quartz is known as the master healer and amplifies any energy or intention. Quartz protects against negativity, attunes to your higher self, and relieves pain. It is considered the master healer due to its ability to amplify healing vibrations of other crystals.
***Warning*** This product contains Walnut Shells. Those with nut allergies should use caution.
Net wt 5 oz
Ingredients: Sorbitol, Propylene Glycol, Sodium Laureth Sulfate, Stearic Acid, Water, Sodium Hydroxide, Myristic Acid, Sodium Cocoyl Isethionate, Glycerin, Lauric Acid, Shea Butter, Oatmeal, Walnut Powder, Jasmine flowers, Kaolin Clay, Red Oxide, Blue Mica, Green Pigment, Abalone and Sea Fo
Couldn't load pickup availability
Product features
Product features
Materials and care
Materials and care
Merchandising tips
Merchandising tips
Share